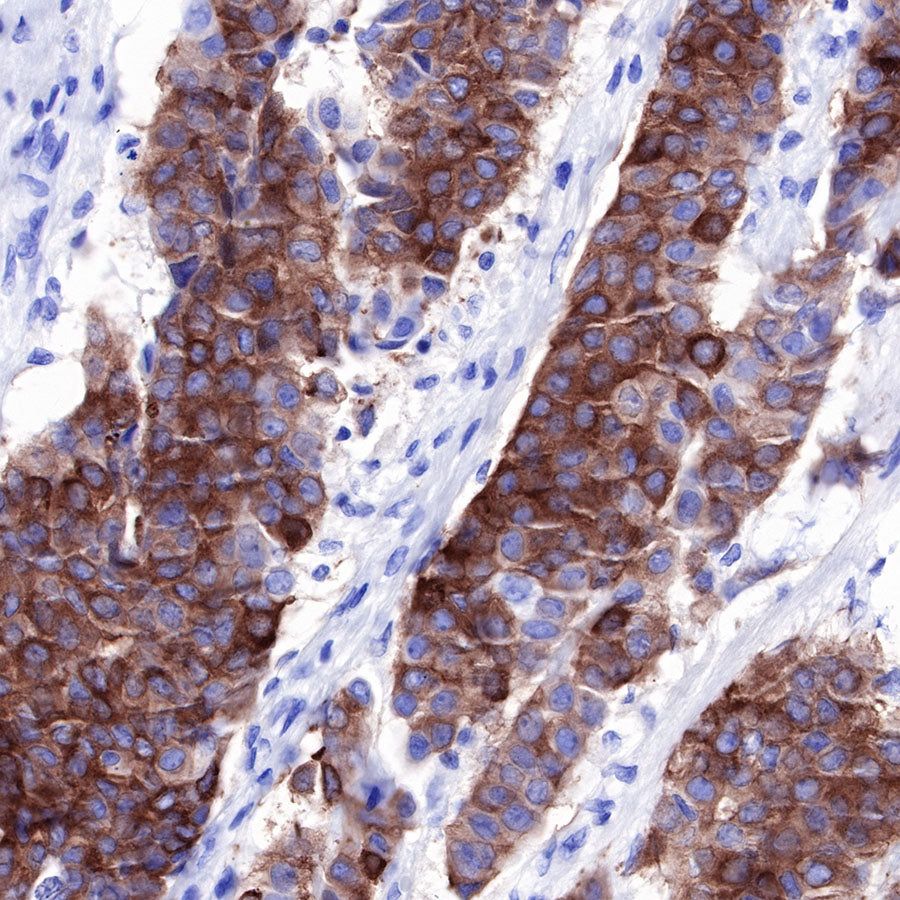
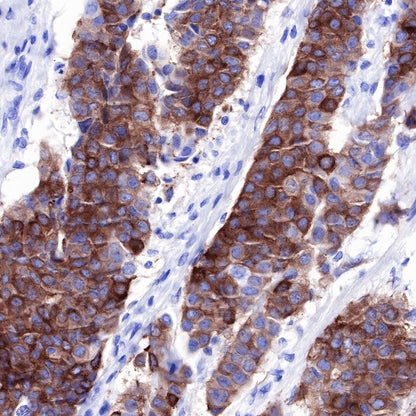
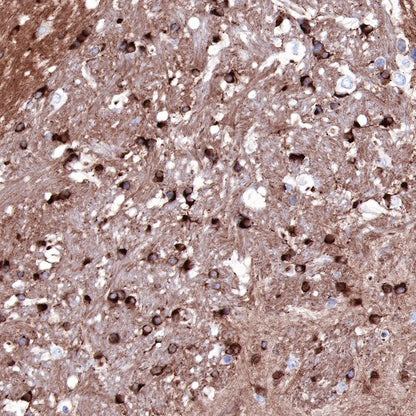

WB result of Tau Rabbit mAb
Primary antibody: Tau Rabbit mAb at 1/1000 dilution
Lane 1: SH-SY5Y whole cell lysate 20 µg
Secondary antibody: Goat Anti-Rabbit IgG, (H+L), HRP conjugated at 1/10000 dilution
Predicted MW: 76 kDa
Observed MW: 45~65 kDa
Product Details
Product Details
Product Specification
Host | Rabbit |
Antigen | Tau |
Synonyms | Tau-F, Tau-4, 2N4R,MAPT |
Immunogen | Recombinant Protein |
Location | Cytoplasm, Secreted, Cell membrane |
Accession | P10636-8 |
Clone Number | SDT-171-67 |
Antibody Type | Rabbit mAb |
Application | WB, IHC-P |
Reactivity | Hu, Ms, Rt |
Purification | Protein A |
Concentration | 0.5 mg/ml |
Physical Appearance | Liquid |
Storage Buffer | PBS, 40% Glycerol, 0.05%BSA, 0.03% Proclin 300 |
Stability & Storage | 12 months from date of receipt / reconstitution, -20 °C as supplied |
Dilution
application | dilution | species |
WB | 1:1000 | |
IHC-P | 1:500 |
Background
Tau is a microtubule-associated protein for which the physiological functions remain a topic of vigorous investigation. Additionally, tau is a central player in the pathogenesis of several diseases such as Alzheimer’s disease and several frontotemporal dementias. A critical variable to understanding tau in physiological and disease contexts is its normal localization within cells of the adult CNS.
Picture
Picture
Western Blot


WB result of Tau Rabbit mAb
Primary antibody: Tau Rabbit mAb at 1/1000 dilution
Lane 1: mouse heart lysate 20 µg
Lane 2: mouse brain lysate 20 µg
Negative control: mouse heart lysate
Secondary antibody: Goat Anti-Rabbit IgG, (H+L), HRP conjugated at 1/10000 dilution
Predicted MW: 76 kDa
Observed MW: 50 kDa
Immunohistochemistry

IHC shows positive staining in paraffin-embedded human breast. Anti-Tau antibody was used at 1/500 dilution, followed by a HRP Polymer for Mouse & Rabbit IgG (ready to use). Counterstained with hematoxylin. Heat mediated antigen retrieval with Tris/EDTA buffer pH9.0 was performed before commencing with IHC staining protocol.

IHC shows positive staining in paraffin-embedded human breast cancer. Anti-Tau antibody was used at 1/500 dilution, followed by a HRP Polymer for Mouse & Rabbit IgG (ready to use). Counterstained with hematoxylin. Heat mediated antigen retrieval with Tris/EDTA buffer pH9.0 was performed before commencing with IHC staining protocol.

IHC shows positive staining in paraffin-embedded human colon. Anti-Tau antibody was used at 1/500 dilution, followed by a HRP Polymer for Mouse & Rabbit IgG (ready to use). Counterstained with hematoxylin. Heat mediated antigen retrieval with Tris/EDTA buffer pH9.0 was performed before commencing with IHC staining protocol.

IHC shows positive staining in paraffin-embedded mouse cerebral cortex. Anti-Tau antibody was used at 1/500 dilution, followed by a HRP Polymer for Mouse & Rabbit IgG (ready to use). Counterstained with hematoxylin. Heat mediated antigen retrieval with Tris/EDTA buffer pH9.0 was performed before commencing with IHC staining protocol.

IHC shows positive staining in paraffin-embedded rat cerebral cortex. Anti-Tau antibody was used at 1/500 dilution, followed by a HRP Polymer for Mouse & Rabbit IgG (ready to use). Counterstained with hematoxylin. Heat mediated antigen retrieval with Tris/EDTA buffer pH9.0 was performed before commencing with IHC staining protocol.